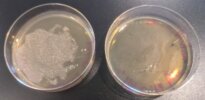
PXL_20250305_191407009 2025 UV Bio Posters
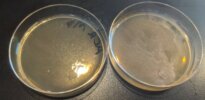
PXL_20250305_191058390 2025 UV Bio Posters

UV Yeast Experiment
Our Biology students designed their own experiments to determine what devices might affect the protection of wild and mutant yeast strains unable to repair their DNA after exposure to UV rays. Would non-UV blocking advertised glasses offer the same protection as proper UV protective sunglasses? Would a camera lens filter out UV rays effectively? Does organic or generic sunscreen offer a different level of protection to the yeast?
The posters they presented below show their experimental results.